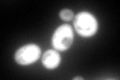
YMR105C
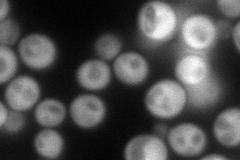
YMR105C
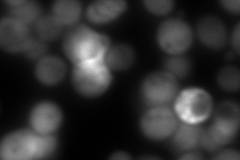
YMR105C
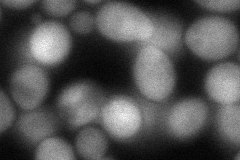
YMR105C
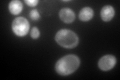
YMR105C

View description
Phosphoglucomutase, catalyzes the conversion from glucose-1-phosphate to glucose-6-phosphate, which is a key step in hexose metabolism; functions as the acceptor for a Glc-phosphotransferase
Localization:
Intensity:
Fold change:
Significance:
-
C’ GFP library in SD
nucleus,cytosol299.5 -
N' NOP1pr-GFP in SD
cytosol156.988 -
N' TEF2pr-mCherry in SD
cytosol75.9342 -
N' NATIVEpr-GFP in SD

cytosol101.387 -
N' TEF2pr-VC and Cyto-VN in SD
cytosol75.0877 -
C’ GFP library in SD+DTT

nucleus,cytosol502.871.67Yes -
C’ GFP library in SD+H2O2

nucleus,cytosol406.771.35No -
C’ GFP library in Starvation Media
nucleus,cytosol529.41.76Yes -
C’ GFP library on the background of Pup2-DaMP

N/A -
C’ GFP library on the background of CCT mutant

N/A0N/AYes
